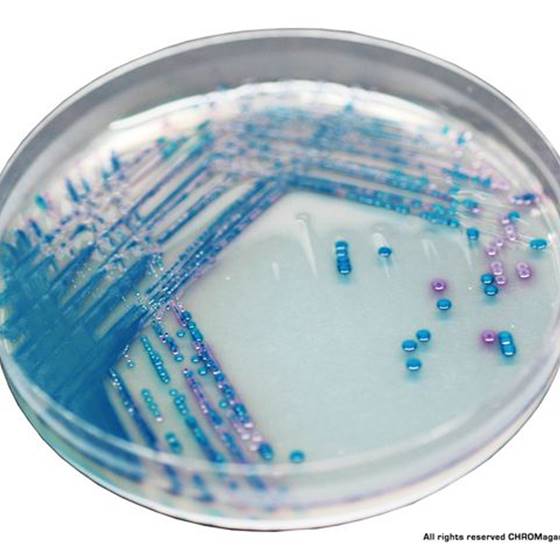

Über das Produkt
Chromogenes Medium zur Detektion von gramnegativen Bakterien mit reduzierter Empfindlichkeit gegenüber den meisten Karbapenemen.
CHROMagar KPC (5L)
Chromogenes Medium zur Detektion von gramnegativen Bakterien mit reduzierter Empfindlichkeit gegenüber den meisten Karbapenemen.